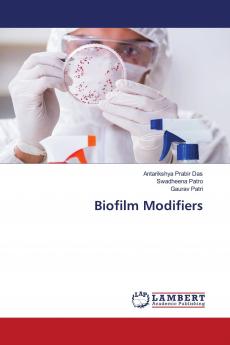
Biofilm Modifiers

English
Paperback
₹5772
(All inclusive*)
Delivery Options
Please enter pincode to check delivery time.
*COD & Shipping Charges may apply on certain items.
Review final details at checkout.
Looking to place a bulk order? SUBMIT DETAILS
Delivery Options
Please enter pincode to check delivery time.
*COD & Shipping Charges may apply on certain items.
Review final details at checkout.
About The Book
Description
Author
Oral biofilms are well structured exhibiting features like channels and projections. Good oral hygiene reducing biofilm accumulation in dentally aware populations has a beneficial effect on caries prevalence but regimens targeted at modifying the ecology of the oral biofilm have not as yet been as reproducibly successful. Ecological approaches to caries prevention often target Streptococcus mutans while the ecological plaque hypothesis and analysis of the new microbial diversity data suggest that single species not even S. mutans mediate the initiation or progression of dental caries. If the oral biofilm is to be beneficially modified better knowledge of the microflora associated with caries initiation especially in the transition from white-spot lesion to cavity is required—not just in terms of which taxa are present but also to understand the physiological characteristics of the biofilm and how they might be interfered with to reduce its cariogenicity at specific tooth sites. Thus this book deals with the recent advancements in modifying ecology of oral biofilms thereby reducing the chances of dental caries and other peridodontal diseases.
Details
ISBN 13
9786204209777
Publication Date
-07-10-2021
Pages
-108
Weight
-151 grams
Dimensions
-150x220x6.15 mm